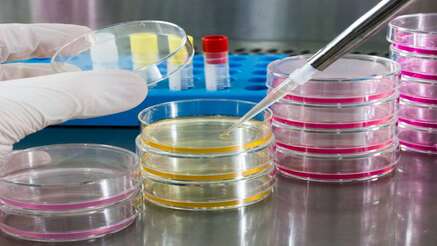

Hospital data breaches could lead to identity theft, financial fraud
Hackers do not always target retail stores and banks; they also target hospitals. By doing so, they can obtain a significant amount of extremely sensitive information. Recent research identifies what... Read More